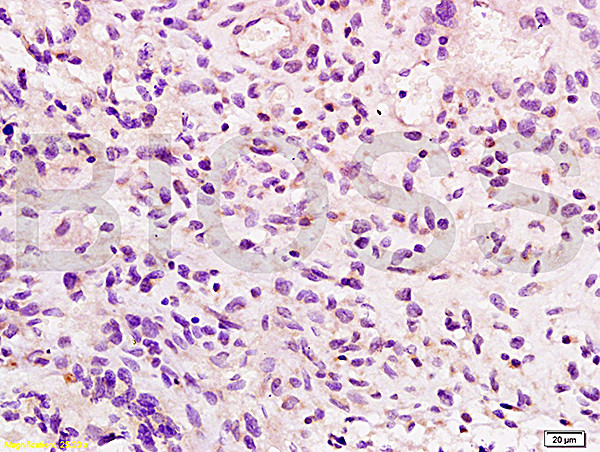
Integrin beta 7 Antibody in Immunohistochemistry (Paraffin) (IHC (P))
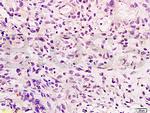
Integrin beta 7 Antibody in Immunohistochemistry (Paraffin) (IHC (P))

Search
Bioss
Integrin beta 7 Polyclonal Antibody
{{$productOrderCtrl.translations['antibody.pdp.commerceCard.promotion.promotions']}}
{{$productOrderCtrl.translations['antibody.pdp.commerceCard.promotion.viewpromo']}}
{{$productOrderCtrl.translations['antibody.pdp.commerceCard.promotion.promocode']}}: {{promo.promoCode}} {{promo.promoTitle}} {{promo.promoDescription}}. {{$productOrderCtrl.translations['antibody.pdp.commerceCard.promotion.learnmore']}}
产品信息
BS-1051R
种属反应
宿主/亚型
分类
类型
抗原
偶联物
形式
浓度
规格
纯化类型
保存液
内含物
保存条件
运输条件
靶标信息
Integrin beta 7 associates with integrin alpha 4 (CD49d) to form the alpha 4 beta 7 integrin LPAM-1, expressed on intraepithelial lymphocytes. It also associates with alpha E (CD103) to form the alpha E beta 7 integrin HML-1, expressed on T cells adjacent to mucosal epithelium and intraepithelial lymphocytes. Ligands for LPAM-1 include VCAM-1 (CD106), MAdCAM-1 and fibronectin, while the ligand of HML-1 is E-cadherin (CD324). Integrin beta 7 plays an important role in the adhesion of leukocytes to endothelial cells promoting the transmigration of leukocytes to extravascular spaces during the inflammatory response.
仅用于科研。不用于诊断过程。未经明确授权不得转售。
篇参考文献 (0)
生物信息学
蛋白别名: Gut homing receptor beta subunit; integrin beta 7 subunit; Integrin beta-7; Integrin beta-P; M290 IEL antigen; unnamed protein product
基因别名: ITGB7; Ly69
UniProt ID: (Human) P26010, (Mouse) P26011
Entrez Gene ID: (Human) 3695, (Rat) 25713, (Mouse) 16421